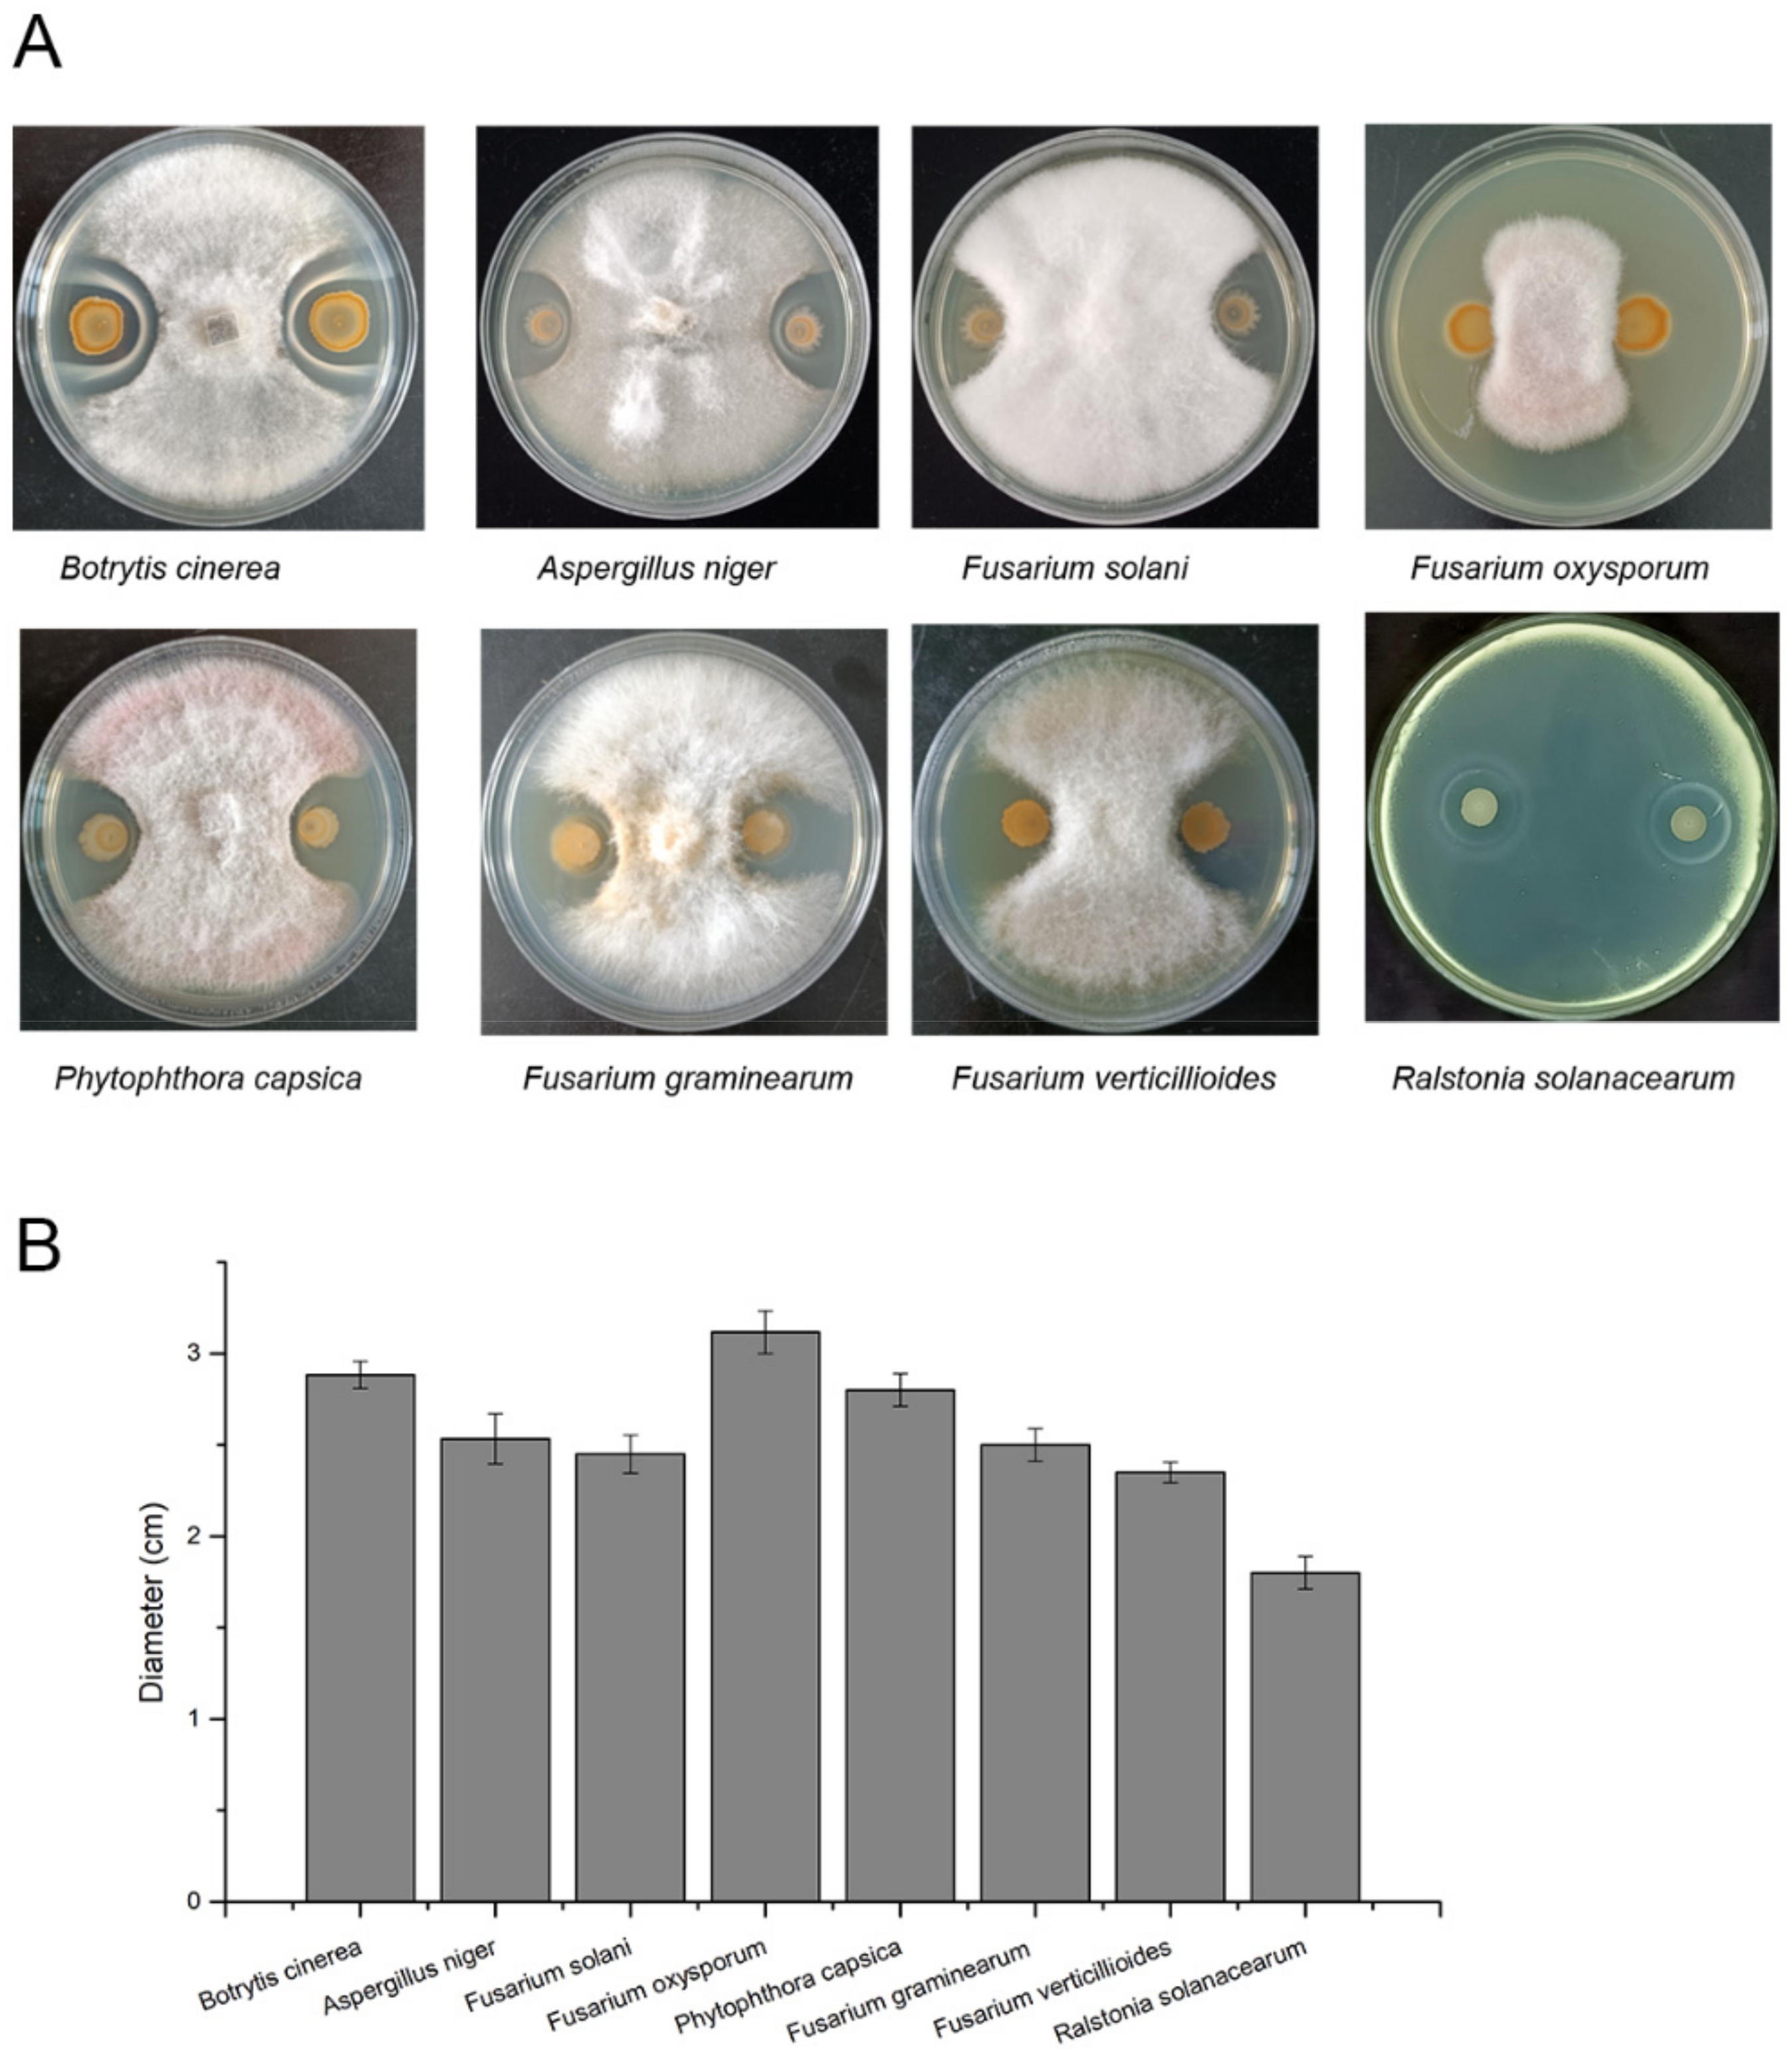
Microorganisms 10 00767 g005 550

The Genome of Bacillus velezensis SC60 Provides Evidence for Its Plant Probiotic Effects
Abstract
:1. Introduction
2. Materials and Methods
2.1. Microbial Strains and Related Medium
2.2. Genomic DNA Preparation, Sequencing and Analysis
2.3. Comparative Analysis of SC60 with Other Bacillus spp.
2.4. Root Colonization of Strain SC60
2.5. Plant Growth-Promoting Assay of Strain SC60
2.6. Plant Pathogens’ Growth Inhibition Assays
2.7. Closely Related Species’ Growth Inhibition Assays
3. Results and Analyses
3.1. Comparative Genome Analysis of Strain SC60 with Bacillus Strains
3.2. Plant Growth-Promoting Traits of SC60
3.3. Secondary Metabolite Cluster Analysis
3.4. Antagonistic Activity against Plant Pathogens
3.5. Antagonistic Activity against Bacillus spp.
4. Discussion
5. Conclusions
Supplementary Materials
Author Contributions
Funding
Institutional Review Board Statement
Informed Consent Statement
Data Availability Statement
Conflicts of Interest
References
- Vejan, P.; Abdullah, R.; Khadiran, T.; Ismail, S.; Boyce, A.N. Role of Plant Growth Promoting Rhizobacteria in Agricultural Sustainability-a Review. Molecules 2016, 21, 573. [Google Scholar] [CrossRef] [PubMed]
- Liu, Y.; Chen, L.; Wu, G.; Feng, H.; Zhang, G.; Shen, Q.; Zhang, R. Identification of Root-Secreted Compounds Involved in the Communication between Cucumber, the Beneficial Bacillus amyloliquefaciens, and the Soil-Borne Pathogen Fusarium Oxysporum. Mol. Plant-Microbe Interact. 2017, 30, 53–62. [Google Scholar] [CrossRef] [PubMed] [Green Version]
- Feng, H.; Zhang, N.; Fu, R.; Liu, Y.; Krell, T.; Du, W.; Shao, J.; Shen, Q.; Zhang, R. Recognition of Dominant Attractants by Key Chemoreceptors Mediates Recruitment of Plant Growth-Promoting Rhizobacteria. Environ. Microbiol. 2019, 21, 402–415. [Google Scholar] [CrossRef] [PubMed] [Green Version]
- Imran, M.; Abulreesh, H.H.; Monjed, M.K.; Elbanna, K.; Samreen; Ahmad, I. Multifarious Functional Traits of Free-Living Rhizospheric Fungi, with Special Reference to Aspergillus spp. Isolated from North Indian Soil, and Their Inoculation Effect on Plant Growth. Ann. Microbiol. 2021, 71, 31. [Google Scholar] [CrossRef]
- Chen, L.; Liu, Y.; Wu, G.; Zhang, N.; Shen, Q.; Zhang, R. Beneficial Rhizobacterium Bacillus amyloliquefaciens SQR9 Induces Plant Salt Tolerance through Spermidine Production. Mol. Plant-Microbe Interact. 2017, 30, 423–432. [Google Scholar] [CrossRef] [Green Version]
- Li, Y.; Shao, J.; Xie, Y.; Jia, L.; Fu, Y.; Xu, Z.; Zhang, N.; Feng, H.; Xun, W.; Liu, Y.; et al. Volatile Compounds from Beneficial Rhizobacteria Bacillus spp. Promote Periodic Lateral Root Development in Arabidopsis. Plant Cell Environ. 2021, 44, 1663–1678. [Google Scholar] [CrossRef]
- Lindsay, D.; Brozel, V.S.; Von Holy, A. Spore Formation in Bacillus subtilis Biofilms. J. Food Prot. 2005, 68, 860–865. [Google Scholar] [CrossRef]
- Murali, M.; Singh, S.B.; Gowtham, H.G.; Shilpa, N.; Prasad, M.; Aiyaz, M.; Amruthesh, K.N. Induction of Drought Tolerance in Pennisetum glaucum by ACC Deaminase Producing PGPR-Bacillus amyloliquefaciens through Antioxidant Defense System. Microbiol. Res. 2021, 253, 126891. [Google Scholar] [CrossRef]
- Sun, B.; Gu, L.; Bao, L.; Zhang, S.; Wei, Y.; Bai, Z.; Zhuang, G.; Zhuang, X. Application of Biofertilizer Containing Bacillus subtilis Reduced the Nitrogen Loss in Agricultural Soil. Soil Biol. Biochem. 2020, 148, 107911. [Google Scholar] [CrossRef]
- Poveda, J.; Gonzalez-Andres, F. Bacillus as a Source of Phytohormones for Use in Agriculture. Appl. Microbiol. Biotechnol. 2021, 105, 8629–8645. [Google Scholar] [CrossRef]
- Talboys, P.J.; Owen, D.W.; Healey, J.R.; Withers, P.J.; Jones, D.L. Auxin Secretion by Bacillus amyloliquefaciens FZB42 Both Stimulates Root Exudation and Limits Phosphorus Uptake in Triticum aestivium. BMC Plant Biol. 2014, 14, 51. [Google Scholar] [CrossRef] [PubMed] [Green Version]
- Kumar, V.; Singh, P.; Jorquera, M.A.; Sangwan, P.; Kumar, P.; Verma, A.K.; Agrawal, S. Isolation of Phytase-Producing Bacteria from Himalayan Soils and Their Effect on Growth and Phosphorus Uptake of Indian Mustard (Brassica juncea). World J. Microbiol. Biotechnol. 2013, 29, 1361–1369. [Google Scholar] [CrossRef] [PubMed]
- Mehta, P.; Walia, A.; Kulshrestha, S.; Chauhan, A.; Shirkot, C.K. Efficiency of Plant Growth-Promoting P-Solubilizing Bacillus Circulans CB7 for Enhancement of Tomato Growth under Net House Conditions. J. Basic Microbiol. 2015, 55, 33–44. [Google Scholar] [CrossRef]
- Chen, Y.; Yang, H.; Shen, Z.; Ye, J. Whole-Genome Sequencing and Potassium-Solubilizing Mechanism of Bacillus aryabhattai SK1-7. Front. Microbiol. 2022, 12, 722379. [Google Scholar] [CrossRef] [PubMed]
- Liu, D.; Yang, Q.; Ge, K.; Hu, X.; Qi, G.; Du, B.; Liu, K.; Ding, Y. Promotion of Iron Nutrition and Growth on Peanut by Paenibacillus illinoisensis and Bacillus sp. Strains in Calcareous Soil. Braz. J. Microbiol. 2017, 48, 656–670. [Google Scholar] [CrossRef]
- Verma, S.; Kumar, M.; Kumar, A.; Das, S.; Chakdar, H.; Varma, A.; Saxena, A.K. Diversity of Bacterial Endophytes of Maize (Zea Mays) and Their Functional Potential for Micronutrient Biofortification. Curr. Microbiol. 2022, 79, 6. [Google Scholar] [CrossRef]
- Wang, D.; Xu, Z.; Zhang, G.; Xia, L.; Dong, X.; Li, Q.; Liles, M.R.; Shao, J.; Shen, Q.; Zhang, R. A Genomic Island in a Plant Beneficial Rhizobacterium Encodes Novel Antimicrobial Fatty Acids and a Self-Protection Shield to Enhance Its Competition. Environ. Microbiol. 2019, 21, 3455–3471. [Google Scholar] [CrossRef]
- Pandin, C.; Le Coq, D.; Deschamps, J.; Vedie, R.; Rousseau, T.; Aymerich, S.; Briandet, R. Complete Genome Sequence of Bacillus velezensis QST713: A Biocontrol Agent That Protects Agaricus bisporus Crops against the Green Mould Disease. J. Biotechnol. 2018, 278, 10–19. [Google Scholar] [CrossRef]
- Blin, K.; Shaw, S.; Steinke, K.; Villebro, R.; Ziemert, N.; Lee, S.Y.; Medema, M.H.; Weber, T. AntiSMASH 5.0: Updates to the Secondary Metabolite Genome Mining Pipeline. Nucleic Acids Res. 2019, 47, W81–W87. [Google Scholar] [CrossRef] [Green Version]
- Choi, J.; Nam, J.; Seo, M.-H. Complete Genome Sequence of Bacillus velezensis NST6 and Comparison with the Species Belonging to Operational Group B. amyloliquefaciens. Genomics 2021, 113, 380–386. [Google Scholar] [CrossRef]
- Wu, G.; Liu, Y.; Xu, Y.; Zhang, G.; Shen, Q.; Zhang, R. Exploring Elicitors of the Beneficial Rhizobacterium Bacillus amyloliquefaciens SQR9 to Induce Plant Systemic Resistance and Their Interactions with Plant Signaling Pathways. Mol. Plant-Microbe Interact. 2018, 31, 560–567. [Google Scholar] [CrossRef] [PubMed] [Green Version]
- Abd El-Daim, I.A.; Bejai, S.; Fridborg, I.; Meijer, J. Identifying Potential Molecular Factors Involved in Bacillus amyloliquefaciens 5113 Mediated Abiotic Stress Tolerance in Wheat. Plant Biol. 2018, 20, 271–279. [Google Scholar] [CrossRef] [PubMed]
- Li, B.; Li, Q.; Xu, Z.; Zhang, N.; Shen, Q.; Zhang, R. Responses of Beneficial Bacillus amyloliquefaciens SQR9 to Different Soilborne Fungal Pathogens through the Alteration of Antifungal Compounds Production. Front. Microbiol. 2014, 5, 636. [Google Scholar] [CrossRef] [PubMed] [Green Version]
- Li, Y.; Li, X.; Liu, Y.; Wang, E.T.; Ren, C.; Liu, W.; Xu, H.; Wu, H.; Jiang, N.; Li, Y.; et al. Genetic Diversity and Community Structure of Rhizobia Nodulating Sesbania cannabina in Saline-Alkaline Soils. Syst. Appl. Microbiol. 2016, 39, 195–202. [Google Scholar] [CrossRef]
- Ren, C.-G.; Bai, Y.-J.; Kong, C.-C.; Bian, B.; Xie, Z.-H. Synergistic Interactions between Salt-Tolerant Rhizobia and Arbuscular Mycorrhizal Fungi on Salinity Tolerance of Sesbania Cannabina Plants. J. Plant Growth Regul. 2016, 35, 1098–1107. [Google Scholar] [CrossRef]
- Dang, X.; Xie, Z.; Liu, W.; Sun, Y.; Liu, X.; Zhu, Y.; Staehelin, C. The Genome of Ensifer Alkalisoli YIC4027 Provides Insights for Host Specificity and Environmental Adaptations. BMC Genom. 2019, 20, 643. [Google Scholar] [CrossRef] [Green Version]
- Luo, R.; Liu, B.; Xie, Y.; Li, Z.; Huang, W.; Yuan, J.; He, G.; Chen, Y.; Pan, Q.; Liu, Y.; et al. SOAPdenovo2: An Empirically Improved Memory-Efficient Short-Read de Novo Assembler. GigaScience 2012, 1, 18. [Google Scholar] [CrossRef]
- Wick, R.R.; Judd, L.M.; Gorrie, C.L.; Holt, K.E. Unicycler: Resolving Bacterial Genome Assemblies from Short and Long Sequencing Reads. PLoS Comput. Biol. 2017, 13, e1005595. [Google Scholar] [CrossRef] [Green Version]
- Delcher, A.L.; Bratke, K.A.; Powers, E.C.; Salzberg, S.L. Identifying Bacterial Genes and Endosymbiont DNA with Glimmer. Bioinformatics 2007, 23, 673–679. [Google Scholar] [CrossRef]
- Bairoch, A.; Apweiler, R. The SWISS-PROT Protein Sequence Database and Its Supplement TrEMBL in 2000. Nucleic Acids Res. 2000, 28, 45–48. [Google Scholar] [CrossRef]
- Finn, R.D.; Bateman, A.; Clements, J.; Coggill, P.; Eberhardt, R.Y.; Eddy, S.R.; Heger, A.; Hetherington, K.; Holm, L.; Mistry, J.; et al. Pfam: The Protein Families Database. Nucleic Acids Res. 2014, 42, D222–D230. [Google Scholar] [CrossRef] [PubMed] [Green Version]
- Kanehisa, M.; Goto, S. KEGG: Kyoto Encyclopedia of Genes and Genomes. Nucleic Acids Res. 2000, 28, 27–30. [Google Scholar] [CrossRef] [PubMed]
- Jensen, L.J.; Julien, P.; Kuhn, M.; von Mering, C.; Muller, J.; Doerks, T.; Bork, P. EggNOG: Automated Construction and Annotation of Orthologous Groups of Genes. Nucleic Acids Res. 2008, 36, D250–D254. [Google Scholar] [CrossRef] [PubMed]
- Bertelli, C.; Laird, M.R.; Williams, K.P.; Lau, B.Y.; Hoad, G.; Winsor, G.L.; Brinkman, F.S.L. IslandViewer 4: Expanded Prediction of Genomic Islands for Larger-Scale Datasets. Nucleic Acids Res. 2017, 45, W30–W35. [Google Scholar] [CrossRef] [PubMed]
- Alikhan, N.-F.; Petty, N.K.; Ben Zakour, N.L.; Beatson, S.A. BLAST Ring Image Generator (BRIG): Simple Prokaryote Genome Comparisons. BMC Genom. 2011, 12, 402. [Google Scholar] [CrossRef] [Green Version]
- Emms, D.M.; Kelly, S. OrthoFinder: Phylogenetic Orthology Inference for Comparative Genomics. Genome Biol. 2019, 20, 238. [Google Scholar] [CrossRef] [Green Version]
- Xiong, Q.; Liu, D.; Zhang, H.; Dong, X.; Zhang, G.; Liu, Y.; Zhang, R. Quorum Sensing Signal Autoinducer-2 Promotes Root Colonization of Bacillus Velezensis SQR9 by Affecting Biofilm Formation and Motility. Appl. Microbiol. Biotechnol. 2020, 104, 7177–7185. [Google Scholar] [CrossRef]
- Xu, W.; Zhang, L.; Goodwin, P.H.; Xia, M.; Zhang, J.; Wang, Q.; Liang, J.; Sun, R.; Wu, C.; Yang, L. Isolation, Identification, and Complete Genome Assembly of an Endophytic Bacillus Velezensis YB-130, Potential Biocontrol Agent against Fusarium Graminearum. Front. Microbiol. 2020, 11, 598285. [Google Scholar] [CrossRef]
- Weiner, R.; Langille, S.; Quintero, E. Structure, Function and Immunochemistry of Bacterial Exopolysaccharides. J. Indust. Microbiol. 1995, 15, 339–346. [Google Scholar] [CrossRef]
- Romero, D.; Aguilar, C.; Losick, R.; Kolter, R. Amyloid Fibers Provide Structural Integrity to Bacillus subtilis Biofilms. Proc. Natl. Acad. Sci. USA 2010, 107, 2230–2234. [Google Scholar] [CrossRef] [Green Version]
- Hobley, L.; Ostrowski, A.; Rao, F.V.; Bromley, K.M.; Porter, M.; Prescott, A.R.; MacPhee, C.E.; Van Aalten, D.M.F.; Stanley-Wall, N.R. BslA Is a Self-Assembling Bacterial Hydrophobin That Coats the Bacillus Subtilis Biofilm. Proc. Natl. Acad. Sci. USA 2013, 110, 13600–13605. [Google Scholar] [CrossRef] [PubMed] [Green Version]
- Stanley, N.R.; Lazazzera, B.A. Defining the Genetic Differences between Wild and Domestic Strains of Bacillus subtilis That Affect Poly-Gamma-DL-Glutamic Acid Production and Biofilm Formation. Mol. Microbiol. 2005, 57, 1143–1158. [Google Scholar] [CrossRef] [PubMed]
- Shao, J.; Li, S.; Zhang, N.; Cui, X.; Zhou, X.; Zhang, G.; Shen, Q.; Zhang, R. Analysis and Cloning of the Synthetic Pathway of the Phytohormone Indole-3-Acetic Acid in the Plant-Beneficial Bacillus amyloliquefaciens SQR9. Microb. Cell Fact. 2015, 14, 130. [Google Scholar] [CrossRef] [PubMed] [Green Version]
- Roy, M.P.; Datta, S.; Ghosh, S. A Novel Fxtracellular Low-Temperature Active Phytase from Bacillus aryabhattai RS1 with Potential Application in Plant Growth. Biotechnol. Prog. 2017, 33, 633–641. [Google Scholar] [CrossRef]
- Bae, S.-J.; Kim, S.; Park, H.J.; Kim, J.; Jin, H.; Kim, B.; Hahn, J.-S. High-Yield Production of (R)-Acetoin in Saccharomyces Cerevisiae by Deleting Genes for NAD(P)H-Dependent Ketone Reductases Producing Meso-2,3-Butanediol and 2,3-Dimethylglycerate. Metab. Eng. 2021, 66, 68–78. [Google Scholar] [CrossRef]
- Wilson, D.N. Ribosome-Targeting Antibiotics and Mechanisms of Bacterial Resistance. Nat. Rev. Microbiol. 2014, 12, 35–48. [Google Scholar] [CrossRef]
- Koumoutsi, A.; Chen, X.-H.; Henne, A.; Liesegang, H.; Hitzeroth, G.; Franke, P.; Vater, J.; Borriss, R. Structural and Functional Characterization of Gene Clusters Directing Nonribosomal Synthesis of Bioactive Cyclic Lipopeptides in Bacillus amyloliquefaciens Strain FZB42. J. Bacteriol. 2004, 186, 1084–1096. [Google Scholar] [CrossRef] [Green Version]
- Xia, L.; Miao, Y.; Cao, A.; Liu, Y.; Liu, Z.; Sun, X.; Xue, Y.; Xu, Z.; Xun, W.; Shen, Q.; et al. Biosynthetic Gene Cluster Profiling Predicts the Positive Association between Antagonism and Phylogeny in Bacillus. Nat. Commun. 2022, 13, 1023. [Google Scholar] [CrossRef]

| Feature | B. velezensis SC60 |
|---|---|
| Genome (bp) | 3,962,671 bp |
| G + C (%) | 46.46% |
| CDS number | 4079 |
| Average gene length (bp) | 863.62 |
| rRNA | 27 |
| tRNA | 89 |
| sRNA | 83 |
| Genes assigned to COG | 2896 |
| prophage regions | 3 |
| Strains | GenBank Accession No. | ANI (%) | dDDH (%) | GC (%) | Size (bp) |
|---|---|---|---|---|---|
| Bacillus velezensis SC60 | NZ_CP072311 | 100 | 100 | 46.46 | 3,962,671 |
| Bacillus velezensis NJN6 | NZ_CP007165 | 99.21 | 96.80 | 46.60 | 4,052,546 |
| Bacillus velezensis CAU B946 | NC_016784.1 | 99.11 | 97.50 | 46.50 | 4,019,861 |
| Bacillus velezensis IT-45 | NC_020272 | 98.99 | 97.00 | 46.62 | 3,928,857 |
| Bacillus velezensis SYBC_H47 | NZ_CP017747 | 98.15 | 93.60 | 46.40 | 3,884,433 |
| Bacillus velezensis UCMB5036 | NC_020410.1 | 97.68 | 94.90 | 46.60 | 3,910,324 |
| Bacillus velezensis UCMB5113 | NC_022081 | 97.63 | 94.20 | 46.70 | 3,889,532 |
| Bacillus velezensis LDO2 | NZ_CP029034.1 | 97.60 | 94.30 | 46.50 | 3,947,271 |
| Bacillus velezensis NAU-B3 | NC_022530.1 | 97.52 | 91.20 | 45.99 | 4,196,170 |
| Bacillus velezensis FZB42 | NC_009725 | 97.52 | 93.80 | 46.50 | 3,918,596 |
| Bacillus velezensis SQR9 | NZ_CP006890 | 97.49 | 92.10 | 46.10 | 4,117,023 |
| Bacillus velezensis CC09 | NZ_CP015443 | 97.49 | 91.80 | 46.10 | 4,167,153 |
| Bacillus velezensis UCMB5033 | NC_022075 | 97.45 | 92.10 | 46.20 | 4,071,167 |
| Bacillus amyloliquefaciens DSM_7 | NC_014551 | 93.29 | 78.50 | 46.10 | 3,980,199 |
| Bacillus amyloliquefaciens TA208 | NC_017188 | 93.23 | 78.70 | 45.80 | 3,937,511 |
| Bacillus subtilis 168 | NZ_CP010052 | 76.26 | 28.70 | 43.50 | 4,215,619 |
| Bacillus subtilis NCIB3610. | NZ_CP020102 | 76.26 | 28.70 | 43.50 | 4,215,607 |
| PGPR Traits | Gene ID | Gene Name | Function |
|---|---|---|---|
| Colonization traits | |||
| Chemotaxis and motility | gene0785 | yfmS | methyl-accepting chemotaxis protein |
| gene1113 | hemAT | methyl-accepting chemotaxis protein | |
| gene1482 | mcpC | methyl-accepting chemotaxis protein | |
| gene3157 | tlpB | methyl-accepting chemotaxis protein | |
| gene3158 | mcpA | methyl-accepting chemotaxis protein | |
| gene3159 | tlpA | methyl-accepting chemotaxis protein | |
| gene3160 | mcpB | methyl-accepting chemotaxis protein | |
| gene1720–1751 | fla-che operon | Flagellar biosynthesis, chemotaxis protein | |
| Biofilm | gene3492–3506 | epsA-O | polysaccharide biosynthesis protein |
| gene2571–2573 | tapA-sipW-tasA | amyloid fibers biosynthesis protein | |
| gene3142 | yuaB | biofilm-surface layer protein | |
| gene3657–3659 | pgsA-C | γ-poly-glutamate biosynthesis protein | |
| Quorum sensing | gene3211–3214 | comAPXQ | Quorum sensing |
| gene3093 | luxS | Autoinducer 2 (AI-2) synthesis protein | |
| plant-growth-promoting factors | |||
| Indole-3-acetic acid (IAA) | gene2346–2351 | trpABFCDE | tryptophan biosynthesis operon |
| gebe3897 | ysne | tryptophan acetyltransferase | |
| phytase | gene2162 | phy | phytase biosynthesis protein |
| acetoin | gene3672–3674 | alsDSR | acetoin biosynthesis operon |
| Bacillus velezensis SC60 | Presence (+) or Absence (−) of Secondary Metabolites Clusters in Bacillus Strains | ||||||||
|---|---|---|---|---|---|---|---|---|---|
| Cluster Number | Synthetase | Predicted Large Cluster Position | bp | Metabolites | MIBiG ID (% of Genes Show Similarity) | FZB42 | SQR9 | DSM7 | 168 |
| 1 | nrps | 305,409–370,816 | 65,407 | Surfactin | BGC0000433 (82%) | + | + | + | + |
| 2 | ladderane | 647,464–688,663 | 41,199 | Plantazolicin | BGC0000569 (91%) | + | − | − | − |
| 3 | PKS-like | 905,286–946,530 | 41,244 | Butirosin | BGC0000693 (7%) | + | + | + | − |
| 4 | terpene | 1,028,575–1,049,315 | 20,740 | - | - | + | + | + | − |
| 5 | transatpks | 1,354,640–1,440,527 | 85,887 | Macrolactin | BGC0000181 (100%) | + | + | − | − |
| 6 | transatpks-nrps | 1,666,678–1,769,379 | 102,701 | Bacillaene | BGC0001089 (100%) | + | + | + | + |
| 7 | transatpks-nrps | 1,833,815–1,971,640 | 137,825 | Fengycin | BGC0001095 (100%) | + | + | + | + |
| 8 | terpene | 1,994,479–2,016,362 | 21,883 | - | - | + | + | + | + |
| 9 | t3pks | 2,126,023–2,167,121 | 41,098 | - | - | + | + | + | + |
| 10 | transatpks | 2,326,876–2,427,336 | 100,460 | Difficidin | BGC0000176 (100%) | + | + | − | − |
| 11 | bacteriocin-nrps | 3,053,922–3,120,713 | 66,791 | Bacillibactin | BGC0000309 (100%) | + | + | + | + |
| 12 | lantipeptide | 3,269,802–3,296,120 | 26,318 | - | - | − | − | − | − |
| 13 | NRPS | 3,626,355–3,667,771 | 41,416 | Bacilysin | BGC0001184 (100%) | + | + | + | + |
Publisher’s Note: MDPI stays neutral with regard to jurisdictional claims in published maps and institutional affiliations. |
© 2022 by the authors. Licensee MDPI, Basel, Switzerland. This article is an open access article distributed under the terms and conditions of the Creative Commons Attribution (CC BY) license (https://creativecommons.org/licenses/by/4.0/).
Share and Cite
Dong, X.; Tu, C.; Xie, Z.; Luo, Y.; Zhang, L.; Li, Z. The Genome of Bacillus velezensis SC60 Provides Evidence for Its Plant Probiotic Effects. Microorganisms 2022, 10, 767. https://doi.org/10.3390/microorganisms10040767
Dong X, Tu C, Xie Z, Luo Y, Zhang L, Li Z. The Genome of Bacillus velezensis SC60 Provides Evidence for Its Plant Probiotic Effects. Microorganisms. 2022; 10(4):767. https://doi.org/10.3390/microorganisms10040767
Chicago/Turabian StyleDong, Xiaoyan, Chen Tu, Zhihong Xie, Yongming Luo, Lei Zhang, and Zhaoyi Li. 2022. "The Genome of Bacillus velezensis SC60 Provides Evidence for Its Plant Probiotic Effects" Microorganisms 10, no. 4: 767. https://doi.org/10.3390/microorganisms10040767
APA StyleDong, X., Tu, C., Xie, Z., Luo, Y., Zhang, L., & Li, Z. (2022). The Genome of Bacillus velezensis SC60 Provides Evidence for Its Plant Probiotic Effects. Microorganisms, 10(4), 767. https://doi.org/10.3390/microorganisms10040767

